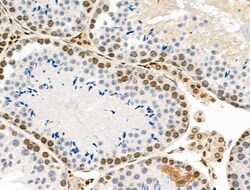

Promotional price valid on web orders only. Your contract pricing may differ. Interested in signing up for a dedicated account number?
Learn More
Learn More
Invitrogen™ Phospho-PRC1 (Thr481) Polyclonal Antibody


Rabbit Polyclonal Antibody
Supplier: Invitrogen™ PA5106104
Description
Antibody detects endogenous levels of PRC1 only when phosphorylated at Thr481.
This gene encodes a protein that is involved in cytokinesis. The protein is present at high levels during the S and G2/M phases of mitosis but its levels drop dramatically when the cell exits mitosis and enters the G1 phase. It is located in the nucleus during interphase, becomes associated with mitotic spindles in a highly dynamic manner during mitosis, and localizes to the cell mid-body during cytokinesis. This protein has been shown to be a substrate of several cyclin-dependent kinases (CDKs). It is necessary for polarizing parallel microtubules and concentrating the factors responsible for contractile ring assembly.
Specifications
| Phospho-PRC1 (Thr481) | |
| Polyclonal | |
| Unconjugated | |
| PRC1 | |
| anaphase spindle elongation 1 homolog; ASE1; carboxypeptidase C PRC1; Carboxypeptidase Y; Carboxypeptidase YSCY; CPD-Y; CPY1; D7Ertd348e; LBC1; MGC1671; MGC3669; prc1; protein regulating cytokinesis 1; protein regulator of cytokinesis 1; YMR297W | |
| Rabbit | |
| sequential chromatography | |
| RUO | |
| 233406, 308761, 9055 | |
| -20°C | |
| Liquid |
| Immunohistochemistry (Paraffin), Western Blot, Immunocytochemistry | |
| 1 mg/mL | |
| PBS with 50% glycerol and 0.02% sodium azide; pH 7.4 | |
| O43663, Q99K43 | |
| PRC1 | |
| A synthesized peptide derived from human PRC1(Accession O43663), corresponding to amino acid residues around phosphorylated Thr481. | |
| 100 μL | |
| Primary | |
| Human, Mouse, Rat | |
| Antibody | |
| IgG |
Product Content Correction
Your input is important to us. Please complete this form to provide feedback related to the content on this product.
Product Title
Spot an opportunity for improvement?Share a Content Correction